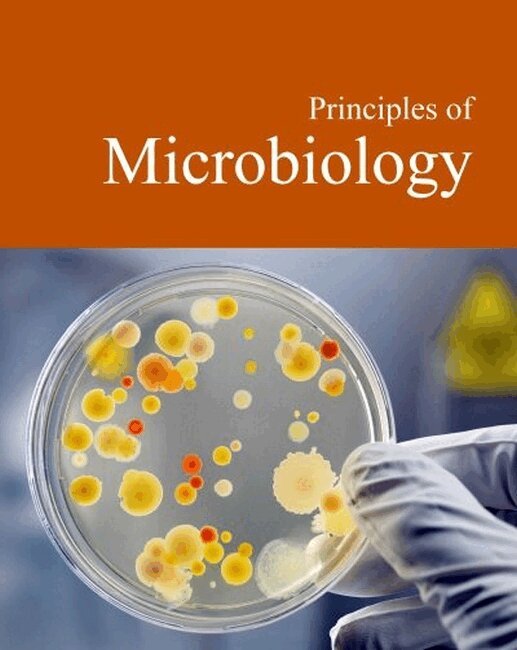

This new edition of ""Notable American Novelists"" presents biographical sketches and analytical overviews of 145 of the best-known American and Canadian writers of long fiction from the 19th and 20th centuries, arranged alphabetically by name. The set's three volumes survey the novelists, whose works are included in core curricula of high school and undergraduate literature studies. Essays on living authors and all the bibliographies in the articles are updated. About two-thirds of the essays are illustrated with portraits of the writers. ""Notable American Novelists"" features often-studied writers ranging from Nathaniel Hawthorne, Mark Twain, Ernest Hemingway, William Faulkner, and Jack London to Joan Didion and J. D. Salinger. Other important nineteenth century figures include Herman Melville, James Fenimore Cooper, Harriet Beecher Stowe, and George Washington Cable. Among the other major twentieth century writers featured are Sinclair Lewis, Norman Mailer, Joyce Carol Oates, John Irving, E. L. Doctorow, Joseph Heller, Toni Morrison, Vladimir Nabokov, Thomas Pynchon, John Steinbeck, Kurt Vonnegut, and John Updike. One can also find essays on such widely read and popular authors as Stephen King, James Michener, Louisa May Alcott, Larry McMurtry, and Anne Rice. A major addition to this new edition is the inclusion of Canadian novelists: Margaret Atwood, Robertson Davies, Frederick Philip Grove, Margaret Laurence, Mordecai Richler, and Sinclair Ross. Each essay begins with a presentation of reference information: the novelist's birth and death dates and a list of the writer's principal works of long fiction, with publication dates. ""Other literary forms"" then briefly describes genres other than long fiction in which the writer has worked, and an ""Achievements"" section encapsulates the author's central contribution and notes major honors and awards. The major sections of the text follow: ""Biography"" provides a sketch of the author's life, and ""Analysis"" looks at the novelist's work in detail; this section examines central and well-known works in the author's canon and illuminates the themes and techniques of primary interest to the novelist. The longest section in the article, ""Analysis"" is divided into subsections on the writer's major individual works. Following ""Analysis"" is a categorized list, ""Other major works,"" that provides titles and dates of works the author has written in genres other than long fiction, including plays, poetry, short fiction, and nonfiction. Each essay concludes with an updated, annotated bibliography. All articles are signed by the principal writer and, where applicable, by the updating contributor. Three helpful reference features are included at the end of volume 3: a glossary entitled ""Terms and Techniques,"" a time line of the writers' birthdates, and an index.